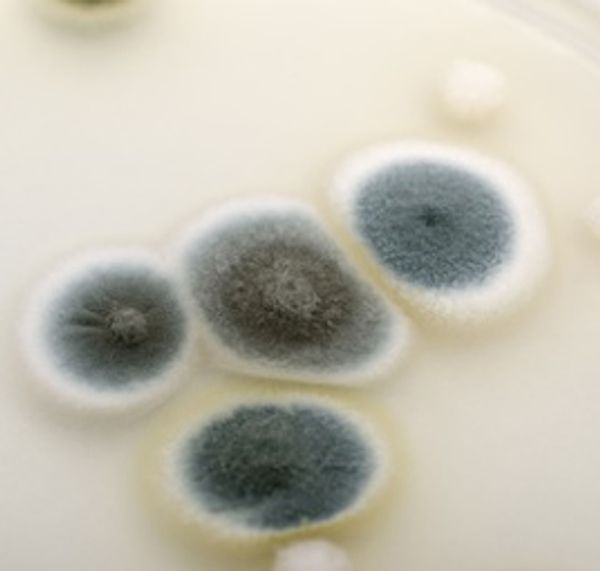

(914) 664-5888 emergency service Flood Emergency New York Yonkers Manhattan
Mold Removal & Remediation
What is Mold?
You thought you knew... but had no idea!
What are Mold Spores?

- Mold itself is a live fungus that thrives in a moist environment.
- Reproduces through spores that travel through the air.
- Found in a variety of colors.
- Can be found both indoors and outdoors.
What are Mold Spores?
You thought you knew... but had no idea!
What are Mold Spores?

- Mold spores allow molds to reproduce and spread.
- Spores release an invisible cloud of spores into the air.
- Most persistent fungi and clings to any form or object.
You thought you knew... but had no idea!
You thought you knew... but had no idea!
You thought you knew... but had no idea!

- Molds can produce toxins that can threaten your health, causing immune system deficiency, asthma and depression.
- Can go undetected in homes, schools, workplaces and any environment that provides moisture.
- Bleach does not remove mold.
Let Us Help!
Testing
Remediate
Removal
- Assessment
- Environmental Testing
- Moisture Mapping
- Provide tangible documentation.
- Yonkers
Removal
Remediate
Removal
- Removal and disposal of contaminated material.
- Microbial contaminant.
- Moisture control.
- New York
- Yonkers
- Manhattan
Remediate
Remediate
Remediate
- Clean and sanitize affected areas.
- Trained technicians investigate and provide best practices to remediate growth.
- Communicate with insurance on your behalf.
- mold remediation
Contact one of our specialist to help you.
Common Types of Mold

Acremonium
- Toxigenic mold type the evolves in its appearance over time
- Typically grows in humidifiers, cooling coils, drain pans and window sealants

Mucor
- Allergenic type of mold that often grows in large patches
- Often grows near or around air conditioning units,HVAC systems, and ducting due to the moisture that builds there

Alternaria
- Most common form of allergenic mold
- Usually grows in damp areas such as showers and sinks

Aspergillus
- common mold in U.S. homes
- over 185 multi colored species

Chaetomium
- Commonly spotted in homes with water damage
- has a cotton like texture and changes colors over time
Cladosporium
- grows in most types of weather
- usually grows in indoor materials like fabric and carpet

Fusarium
- has a high cold tolerance and is able to grow in fridged temperatures
- allergenic and toxigenic ,commonly grows in homes with water damage

Penicillin
- One of the most recognizable types of molds by its blue or green colored surfaces with a close to velvet like texture
- allergenic and often found in water damaged homes and buildings

Stachybotrys
- often known as "black mold"
- extremely toxigenic and can often trigger allergic reactions
- thrives in damp highly humid areas

Trichoderma
- Allergenic mold that is usually white in color with green patches
- Usually grows in houses on damp surfaces and moist areas

Ulocladium
- grows in wet areas and water and is often black in color
- Often found in bathrooms basements and along windows and areas with very high condensation levels
Immediate Property Management Corp
4 Executive Plaza. Ste 132 Yonkers, NY 10701
Copyright © 2022 IPMC - All Rights Reserved.

Cookie Policy
This website uses cookies. By continuing to use this site, you accept our use of cookies.